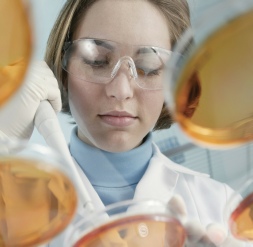
Lab Technician image

Copyright © 2008-12 - Dove Clinic - All rights reserved.
- EECP is an extremely safe and well tolerated treatment
- Occasionally patients experience minor skin irritation due to the rubbing from the cuffs, but this is rarely a problem with padding and use of emollient cream between treatments
- At our clinic, all patients are assessed by a Consultant Cardiologist to ensure their suitability for EECP
- A fully qualified senior nurse is present throughout treatment with a supervisory doctor on site

IS EECP SAFE?